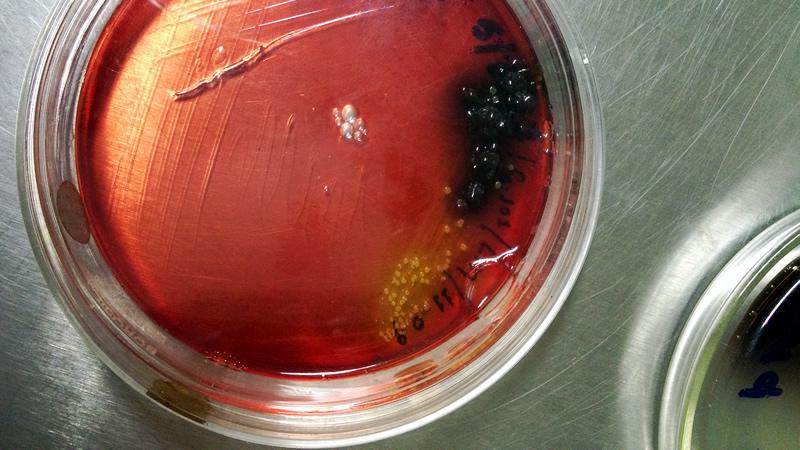
listeria

Listeria monocytogenes, bacteria patógena transmitida por los alimentos, presenta cada vez más visibilidad tanto en lo que se refiere a la dificultad de controlarla en los entornos de la industria alimentaria, como a nivel del impacto de la listeriosis sobre la salud pública. Ante la clara necesidad de mejorar la prevención y el control de esta potencialmente grave enfermedad, la ACSA ha emitido recomendaciones para evitarla.
Listeria monocytogenes se ha convertido en los últimos años en un problema emergente de seguridad en la industria alimentaria, sobre el que existe cada vez una mayor conciencia y conocimiento.
Una vez que esta bacteria accede a una planta de procesado de alimentos es muy difícil erradicarla. Su gran capacidad de persistencia frente a las temperaturas muy bajas, entornos salinos, un amplio rango de pH, asi como a los productos de limpieza y desinfección, aumenta significativamente la probabilidad de que origine contaminaciones cruzadas y recurrentes incluso durante años.
Un ejemplo de ello es el brote de listeriosis que actualmente están investigando el ECDC-EFSA, relacionado con el consumo de productos de pescado ahumados en frío, posiblemente procedentes de una única empresa de procesamiento de alimentos ubicada en Estonia, y que entre julio de 2014 y febrero de 2019 ha afectado a 22 personas en 5 paises de la UE. Cinco de estas personas han fallecido debido a la listeriosis.
También el impacto de esta enfermedad sobre la salud pública va ganando visibilidad, especialmente a partir de que en 2015 se añadiera a la lista de enfermedades de notificación obligatoria en España. Un estudio publicado recientemente en Eurosurveillance sobre la epidemiologia de la listeriosis en España durante el período 1997-2015 muestra un aumento de las hospitalizaciones en este período y hace referencia a una subnotificación considerable de casos, por lo que la incidencia real de la listeriosis es muy probablemente mayor de la que queda registrada.
El incremento en las hospitalizaciones por listeriosis parece estar relacionado con el envejecimiento de la población y una mayor esperanza de vida en pacientes inmunocomprometidos, asi como con la forma de producir, almacenar, distribuir y consumir los alimentos. En todo caso y a pesar de las incertidumbres, los resultados del estudio indican que existe necesidad de mejorar la prevención y el control de esta enfermedad en España.
Prevenir la listeriosis
En este sentido, la Agència Catalana de Seguretat Alimentària (ACSA) ha publicado en su página web algunas recomendaciones para evitar la listeriosis, poniendo especial atención sobre los grupos poblacionales de riesgo, a los que se recomienda tomar precauciones especiales, teniendo en cuenta que la listeriosis es una de las principales causas de mortalidad debida a toxiinfecciones alimentarias.
Es muy importante tener claro cuales son los alimentos con más probabilidades de contaminación por Listeria Monocytogenes y las personas con un mayor riesgo en caso de contraer la listeriosis:

Los alimentos más implicados en los brotes y casos esporádicos de listeriosis son los alimentos listo spara consumir, tanto de origen animal como vegetal, los productos lácteos elaborados con leche no pasterizada, los patés, los productos de la pesca ahumados y los embutidos curados.
La listeria puede contaminar la carne y la leche obtenidas de animales portadores de la bacteria, y su resistencia hace que soporte condiciones anaeróbicas como el vacio o temperaturas de pasteurización bajas y que se multiplique a temperaturas de refrigeración ( de 4ºC a 6ºC) hasta alcanzar cifras significativas si transcurre tiempo suficiente.
También es frecuente encontrarla en alimentos que han sido sometidos a tratamiento térmico y que se vuelven a contaminar posteriormente. Hay que tener en cuenta que es una bacteria muy resistente y puede sobrevivir durante mucho tiempo en las superficies de trabajo, en la maquinaria, en los alimentos y en los frigoríficos domésticos.
Listeriosis en humanos
La infección por Listeria suele cursar con síntomas gastrointestinales, fiebre, cefalea y mialgia, que pueden durar entre 11 y 18 dias. Sin embargo, en algunos casos puede producirse una listeriosis invasiva, en la que la bacteria pasa a la sangre y se puede transmitir al feto por la placenta, o al bebe por el canal de parto, causando sepsis, abortos, partos prematuros, alteraciones fetales y meningoencefalitis. En estos casos, el período de incubación oscila entre 3 y 70 dias (con una media de 21 dias) y el periodo de transmisibilidad es variable.
Las madres infectadas pueden transmitir la bacteria por las secreciones vaginales y la orina entre 7 y 10 dias después del parto, y otras personas infectadas la pueden excretar por las heces durante meses.
Buenas prácticas para prevenir la listeriosis
A partir de aqui, la ACSA recomienda las siguientes prácticas, especialmente a los grupos de riesgo, para evitar contraer la enfermedad:
- Evitar el consumo de alimentos de riesgo o aplicarles un tratamiento térmico a más de 70ºC antes de consumirlos.
- Guardar las sobras de alimentos en la nevera a menos de 4ºC lo antes posible (máximo 2 horas después de su preparación), en recipientes con tapa, y consumirlas antes de que pasen 2 a 3 días. También se pueden congelar el día de la preparación si se tienen que guardar más días.
- Calentar intensamente las sobras antes de consumirlas (mínimo 70ºC)
- Mantener la temperatura de la nevera a 4ºC como máximo.
- Lavar y/o pelar los vegetales que se tengan que consumir crudos justo antes de su consumo. (No preparar con antelación).
- Desinfectar las verduras crudas en una solución de hipoclorito, en dosis indicadas por el fabricante, durante 5 minutos.
- Mantener la máxima higiene de utensilios, manos y superficies y cumplir las cuatro normas fundamentales de seguridad alimentaria (limpiar, separar, cocer y enfriar).
- Respetar las fechas de caducidad de los alimentos que se mantienen refrigerados.
Fuente: ACSA

Higiene Ambiental Consulting, junto con Ambientalys, hemos desarrollado una formación técnica especializada, con el objetivo de formar acerca de cómo se desarrolla esta bacteria dentro de la industria alimentaria, dar a conocer las estrategias, técnicas y productos para controlarla y aprender a identificar los sistemas de detección y prevención más adecuados.
Esta formación se imparte en modalidad on-line y tiene una duración de 25 horas.
Más información sobre el Curso on-line: Listeria: prevención y control en la industria alimentaria